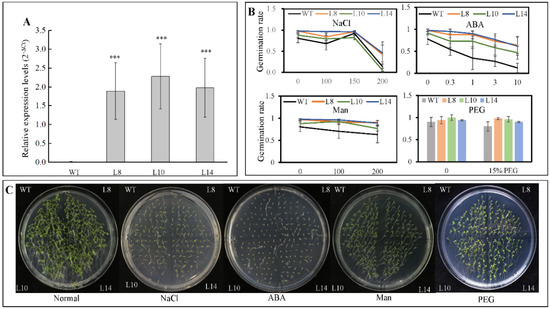

Abstract
WRKY transcription factors (TFs) containing one or two WRKY domains are a class of plant TFs that respond to diverse abiotic stresses and are associated with developmental processes. However, little has been known about the function of WRKY gene in tea plant. In this study, a subgroup IId WRKY gene CsWRKY7 was isolated from Camellia sinensis, which displayed amino acid sequence homology with Arabidopsis AtWRKY7 and AtWRKY15. Subcellular localization prediction indicated that CsWRKY7 localized to nucleus. Cis-acting elements detected in the promotor region of CsWRKY7 are mainly involved in plant response to environmental stress and growth. Consistently, expression analysis showed that CsWRKY7 transcripts responded to NaCl, mannitol, PEG, and diverse hormones treatments. Additionally, CsWRKY7 exhibited a higher accumulation both in old leaves and roots compared to bud. Seed germination and root growth assay indicated that overexpressed CsWRKY7 in transgenic Arabidopsis was not sensitive to NaCl, mannitol, PEG, and low concentration of ABA treatments. CsWRKY7 overexpressing Arabidopsis showed a late-flowering phenotype under normal conditions compared to wild type. Furthermore, gene expression analysis showed that the transcription levels of the flowering time integrator gene FLOWERING LOCUS T (FT) and the floral meristem identity genes APETALA1 (AP1) and LEAFY (LFY) were lower in WRKY7-OE than in the WT. Taken together, these findings indicate that CsWRKY7 TF may participate in plant growth. This study provides a potential strategy to breed late-blooming tea cultivar.
1. Introduction
Plants suffering from diverse abiotic stresses in the developmental process have evolved and obtained a series of mechanisms to combat with these environmental stresses. Majority of transcription factors (TFs) participate in these adaptive mechanisms [1]. WRKY TFs—a large family of transcription factors in plants—are involved in response to multiple stresses and external stimuli [2,3,4].
WRKY transcription factor is named after the WRKY domain, which contains one or two highly conserved WRKYGQK motifs and one zinc-finger motif [5,6]. According to the number of WRKY domains and the type of zinc finger motif, WRKY TFs can be divided into three types: Group I, containing two WRKY domains and one C2H2 zinc-finger structure. Group II, containing one WRKY domain, and sharing the same zinc finger structure with group I. In addition, based on the amino acid sequence of the DNA-binding domain, Group II can be further divided into IIa, IIb, IIc, IId, and IIe subgroups; Group III also contains one WRKY domain, but its zinc finger structure is C2HC [4,7].
SWEET POTATO FACTOR1 (SPF1) specifically binding to W-box, the first defined WRKY TF, negatively regulates the expression of storage proteins and β-amylase in sweet potato [8]. Since then, considerable efforts have been made to unveil the role of WRKY TFs in plant response to biotic and abiotic stresses. In Arabidopsis thaliana, it has been demonstrated that WRKY TFs contribute to pathogen resistance, salinity, heat, and drought stress responses [7,9,10,11]. W-box (TTGACT/C) was present in the promoters of several stress-associated genes. Since WRKY proteins bind to W-box, they induce the expressions of these stress-associated genes [4,5,11,12,13]. Many studies have shown that WRKY proteins participate in secondary metabolism (phenylpropane, alkaloids, and terpenes.), and hormone signaling [10]. Moreover, WRKY proteins have been demonstrated to involve in plant growth processes, such as leaf senescence, shoot branching, trichome, and flowering. For instance, potato ScWRKY1 [14], Arabidopsis TTG2 [15], and MINISEED3 are involved in seed growth [16]; Arabidopsis AtWRKY6, -45, -53, -57, and -70 are involved in senescence regulation [17,18,19,20,21]; Arabidopsis AtWRKY12, -13, -75, -34, mango MIWRKY12, soybean GsWRKY20, and rice DIf1 have been reported to be involved in plant flowering regulation or pollen development [22,23,24,25,26,27]. However, few studies have reported WRKY TFs in tea plant.
Tea plant (Camellia sinensis L.) is an important commercial woody crop. As a nonalcoholic beverage, tea is processed from tea leaves and is widely consumed worldwide. Early blooming in tea plant and adverse environmental factors affect the quality and yields of tea. Increasing studies have demonstrated that WRKY TFs play pivotal roles in plant growth and abiotic stresses. In one previous study, two WRKY TFs—CsWRKY31 and CsWRKY48—were reported to participate in O-methylated catechin biosynthesis in tea plant (Camellia sinensis) [28]. Several CsWRKY genes were induced by diverse stresses such as temperature, ABA, and NaCl [29,30,31]. However, the roles of CsWRKYs in plant growth and development remain unclear. The current study aims to provide a functional characterization of CsWRKY7, a member of the group IId WRKY family in tea plant. CsWRKY7 was a close homolog of Arabidopsis AtWRKY7 and AtWRKY15, two well-characterized Group IId WRKY proteins with important roles in plant defense, leaf senescence, and abiotic stress responses [32,33,34]. When it is exposed to diverse stresses, CsWRKY7 is upregulated and localized to the nuclei in both tobacco leaves and Arabidopsis roots. CsWRKY7-overexpressing Arabidopsis did not respond to abiotic stresses. However, the overexpression of CsWRKY7 delayed flowering. Gene analysis revealed the downregulation of several flowering-related genes in CsWRKY7 overexpression lines. A better understanding of the flowering mechanisms is conducive to breeding late-blooming tea plants.
2. Results
2.1. Isolation and Characterization of CsWRKY7 from C. sinensis
CsWRKY7, one WRKY gene, was amplified from tea leaves cDNA by RT-PCR. This amplified CsWRKY7 contained the complete open reading frame (ORF) of 972 bp encoding 323 amino acids. CsWRKY7 protein had a predicted molecular mass of 35.37 kDa and an isoelectric point of 9.47. Sequence analysis showed that CsWRKY7 in tea plant shared a high similarity (71.94%) to AcWRKY15 in kiwifruit (Genbank: PSS21265). Additionally, CsWRKY7 was found to have a nuclear localization signal (NLS) at 227–230 amino acid region, and have two motifs, namely, HARF structure and a shorter conserved structural motif (C-region which is known as a Ca2+-dependent calmodulin-binding domain) (Figure 1A). Thus, CsWRKY7 was assigned to group IId subfamily. Phylogenetic analysis showed that CsWRKY7 was closely related to AcWRKY15, PtrWRKY7, VvWRKY7, AtWRKY7, and AtWRKY15 (Figure 1B). AtWRKY7 and AtWRKY15 TFs have been reported to be involved in plant defense response to bacterial pathogens, leaf senescence, or mitochondrial-mediated osmotic stress [32,33,34], their homologous genes CsWRKY7 was predicted to be a TF that may participate in plant development and respond to stress treatment.

Figure 1.
Protein sequence alignment and phylogenetic relationship of CsWRKY7 (A) Sequence alignment of the deduced CsWRKY7 protein with other Group IId WRKY homologs. Black lines highlight the conserved region of WRKY. Blue box and arrows highlight the WRKY domain and the zinc-finger motif, respectively. The conserved primary sequences—HARF motif, C-region, and putative NLS—are boxed in red. (B) The phylogenetic tree of CsWRKY7 and 17 other group IId WRKY subfamily members. Accession number for group IId WRKY members: AtWRKY7 (AAK28440), AtWRKY11 (AAK96194), AtWRKY15 (AF224704), AtWRKY17 (AAL13049), AtWRKY21 (AAK28441), AtWRKY39 (AAK96198), AtWRKY74 (AAL35291), AcWRKY7 (PSS36058.1), AcWRKY15 (PSS21265.1), VvWRKY7 (RVX23377.1), PtrWRKY7 (XP_006380693.1), PtrWRKY15 (XP-002310122), GhWRKY17 (HQ651068), TcWRKY7 (EOX91521), TcWRKY15 (XP-007047365), CmWRKY17 (AJF11725), and DzWRKY15 (XP-022740807).
2.2. Sequence Analysis of CsWRKY7 Promoter
According to ‘Shuchazao’ tea genome data, the promoter sequence of CsWRKY7 was amplified by PCR. A 1680 bp CsWRKY7 promoter sequence was cloned and the putative cis-elements were predicted through the PlantCARE database. Two functional elements—TATA-box and CAAT-box—were widely distributed in the promoter region. Additionally, a group of elements which respond to such environmental stresses as phytohormone stress (salicylic acid and auxin), light, plant growth (pollen), and abiotic stresses (anaerobic, sugar, wounding, NaCl, dehydration, and heat) were found (Table 1). Interestingly, many MYB-recognition sites were present in the promoter region of CsWRKY7, and these motifs also existed in dehydration-responsive gene RD22A, indicating that CsWRKY7 might be involved in dehydration stress and be modulated by MYB members. In addition, CsWRKY7 promoter region existed two W-boxes, which specially bind to WRKY TFs. These prediction results indicated that CsWRKY7 TF may play a vital role in stress responses and plant growth through multiple signal transduction pathways.

Table 1.
Hormone-, light-, and stress-responsive elements in the 1680 bp 5′-flanking sequence of CsWRKY7 TF as predicted by the PlantCARE website.
2.3. Subcellular Localization of CsWRKY7
To examine the localization of CsWRKY7, the full-length cDNA of CsWRKY7 was fused to enhanced green fluorescent protein (eGFP). As shown in Figure 2A, CsWRKY7-eGEP was localized to the nucleus when it was transiently expressed in Nicotiana benthamiana leaves. The green fluorescence was observed both in the cell membrane and nucleus in the GFP control vector. Similarly, green fluorescence was also observed in the nucleus of transgenic Arabidopsis seedlings (Figure 2B). These results showed that CsWRKY7 was targeted to the nucleus.

Figure 2.
Subcellular localization analysis of CsWRKY7 protein: (A) GFP alone (upper panel) and CsWRKY7-eGFP (middle panel) were transiently expressed in tobacco epidermal cells. Representative images from left to right in each panel were taken under fluorescence, chlorophyll, transmitted light and an overlay of both channels. Scale bar = 20 μm. (B) The roots of CsWRKY7-eGFP (bottom panel) in transgenic Arabidopsis was used for observation of GFP fluorescence. Representative images from left to right were taken under fluorescence, bright field and an overlay of both channels. Scale bar = 100 μm.
The qRT-PCR result indicated that CsWRKY7 was expressed in all detected tissues. The expression level in old leaves was approximately 4.4 times as high as that in buds (Figure 3A). To investigate the role of CsWRKY7 TF in abiotic stresses, we analyzed the expression patterns of CsWRKY7, when it was exposed to temperature, sodium chloride (NaCl), sucrose (Suc), polyethylene glycol (PEG), and mannitol (Man) stresses. As shown in Figure 3B,C, in leaves, CsWRKY7 was downregulated under high temperature stress, especially at 8 h, its expression level decreased by 65%. When exposed to low temperature, the expression level of CsWRKY7 was not significantly changed at 4 h or 12 h. However, the expression level of CsWRKY7 was upregulated under the treatments of NaCl, Man, and PEG. For example, its expression level increased gradually after NaCl and PEG treatment for 3 h, reaching a peak of 3.26- and 6.23- fold at 72 h, respectively. Though two sugar-responsive elements existed in the promoter region, no significant difference in the expression level of CsWRKY7 after sucrose treatment. In order to investigate whether CsWRKY7 expression was regulated by phytohormones, two-year-old tea plants were exposed to the major plant hormones including indolyl-3-acetic acid (IAA), naphthalene-1-acetic acid (NAA), 2,4-dichlorophenoxyacetic acid (2,4-D), abscisic acid (ABA), methyl jasmonate (MeJA), salicylic acid (SA), and gibberellins (GA). As presented in Figure 3D, the expression level of CsWRKY7 was elevated under these hormone treatments except IAA. These results implied that CsWRKY7 might be involved in the regulation of abiotic stress and hormones networks.

Figure 3.
Relative expression levels of CsWRKY7 in tea plants (A) Tissue expression profiles of CsWRKY7 in ‘Longjing 43’. Different tissues include bud, 1st leaf, 2nd leaf, 3rd leaf, old leaf, flower, stem, and root. The expression levels of CsWRKY7 in different tissues were compared with the bud. (B) The transcript levels of CsWRKY7 under cold (4 °C) and heat (38 °C). CsWRKY7 expression levels are detected at four different time points (0, 4, 8 and 12 h) post-temperature stress treatment. (C) Relative expression levels of CsWRKY7 under different abiotic stress. Two-year-old tea seedlings were treated with 150 mM NaCl, 90 mM sucrose (Suc), 10% (w/v) PEG4000 (PEG) and 90 mM mannitol (Man), and samples were harvested at the time intervals indicated. (D) The transcript levels of CsWRKY7 under various phytohormone, including 100 μM indolyl-3-acetic acid (IAA), 5 μM naphthalene-1-acetic acid (NAA), 5 μM 2,4-dichlorophenoxyacetic acid (2,4-D), 100 μM abscisic acid (ABA), 50 μM methyl jasmonate (MeJA), 5 mM salicylic acid (SA), and 100 μM gibberellins (GA), which were added to the culture solution, the functional leaves were harvested at 0, 3, 6, or 24 h post-treatment. Treated samples at 0 h served as controls. Error bars represent ± S.E. for three independent experiments. The significant level is presented by the asterisks (* p < 0.05, ** p < 0.01).
2.4. Overexpression of CsWRKY7 Affects Flowering in Transgenic Arabidopsis
Seed Germination and Root Growth in Transgenic Plants under Abiotic Stresses
To assess the function of CsWRKY7 TF, an expression construct pH7FGW2.0-CsWRKY7 was transformed into A. thaliana. Three homozygous transgenic lines—L8, L10, and L14—were confirmed by real-time PCR with Actin-2 gene serving as an internal reference. As shown in Figure 4A, the CsWRKY7 transcript levels were significantly higher in transgenic lines than in wild type.
Figure 4.
Germination rates of CsWRKY7-overexpressing Arabidopsis lines under different stress conditions (A) Expression of CsWRKY7 in the leaves of WT and three transgenic lines (L8, L10, and L14), respectively. Data are shown as the mean ± S.E. (n = 3). (B) The germination rate of WT and transgenic lines. Their seeds grown on the 1/2 MS supplied with different concentrations of NaCl, ABA, mannitol and PEG for 4 days. Experiments were performed in five biological replicates. Fifty seeds of each WT and three transgenic lines were germinated in one replicate. Data are shown as the mean ± S.E. (C) Germination performance of WT and transgenic lines were taken under normal conditions, 150 mM NaCl, 0.3 μM ABA, 200 mM mannitol, and 15% PEG treatment for 7 days. Asterisk indicated that the expression level is significantly different from the value of the control (‘***’ p < 0.001).
Since CsWRKY7 responds to abiotic stress and hormone treatments, seed germination was tested with WT and homozygous 35S::CsWRKY7 transgenic lines to determine the specific role of CsWRKY7 TF in abiotic stress. Though the germination rate of overexpressing lines was higher than that of WT (Figure 4B,C), the difference was not statistically significant under normal growth condition or under abiotic stresses, suggesting that CsWRKY7 overexpressing lines may not be sensitive to the above induction during seed germination. No significant difference in root growth was observed between WT and overexpressing lines in the presence of different stress media (Figure 5). However, the root elongation of 35S::CsWRKY7 lines were higher than that of WT with 1/2 MS medium, indicating that CsWRKY7 might promote root growth at the seedling stage under normal growth condition.

Figure 5.
Root growth of CsWRKY7-overexpressing Arabidopsis lines under different stress conditions. Seeds were germinated for 4 days on 1/2 MS medium, and the seedlings were then transferred to 1/2 MS medium with or without different treatment for 10 days. (A) Normal condition, (B) 150 mM NaCl treatment, (C) 0.3 μM ABA treatment, (D) 200 mM mannitol treatment, and (E) 15%PEG6000 treatment, and (F) root length were measured at 10 d after the transfer, each line included three seedlings, experiments were performed in four biological replicates. Data are represented as the mean ± SE of 12 seedlings. The significant level is presented by the asterisks (* p < 0.05).
2.5. CsWRKY7 Overexpressing Lines Exhibit the Phenotype of Delayed Flowering
In order to investigate whether CsWRKY7 TF participated in plant growth and development, the phenotype of CsWRKY7-overexpressing lines and WT was observed during plant growth process. As shown in Figure 6A, B, WT plants bolt earlier than transgenic lines after 25-day growth. When wide-type plants were in silique stage, CsWRKY7 overexpressing plants were in bolting stage or vegetative growth stage after 35-day growth. To elucidate the regulation mechanism of CsWRKY7 in flowering, several flowering-related genes was analyzed (Figure 6C). SUPPRESSOR OF CONSTANS 1 (SCO1), a floral integrator, was significantly induced in 35S::CsWRKY7 lines compared to WT. No noticeable difference in the relative expression level of CONSTANS (CO) gene that the central regulators in the photoperiod pathway was observed between WT and transgenic lines. As a long-distance transport signal, FLOWERING LOCUS T (FT) was significantly downregulated in transgenic lines. Simultaneously, two important genes related to inflorescence meristem—APETALA1 (AP1) and LEAFY (LFY)—were significantly suppressed in Line 8. The expression levels of AP1 and LFY were downregulated by 64% and 60%, respectively. However, a flowering inhibitor, FLOWERING LOCUS C (FLC), was significantly downregulated in overexpressing lines, while its homologous gene FLOWERING LOCUS M (FLM) was upregulated in 35S::CsWRKY7 lines, compared to WT. Therefore, we speculate that CsWRKY7 delay flowering time might through inhibiting the transcription level of AP1 and LFY.

Figure 6.
Identification of the CsWRKY7 in transgenic Arabidopsis. (A,B) Overexpression of CsWRKY7 delayed Arabidopsis flowering in different developmental stages: (A) Representative photographs of 25-day-old-plant of WT and transgenic lines (L8, L10, and L14) growing in normal conditions. (B) 35-day-old-plant. Each line included four seedlings. Experiments were performed in five biological replicates. (C) Expression patterns of flowering-related genes in CsWRKY7-overexpressing and wild type Arabidopsis. Leaf samples were harvested from 25-day-old transgenic lines and WT. The error bars indicate the means ± S.E. (n = 5), * indicates that the differences are significant (p < 0.05), ** indicate that the differences are highly significant (p < 0.01).
3. Discussion
WRKY TFs widely participate in plant stress responses and plant growth and development. This study indicated that CsWRKY7 is involved in abiotic stresses. Constitutive overexpression of CsWRKY7 not only promotes root growth, but also delays the flowering time in transgenic Arabidopsis plants by suppressing flowering-related genes.
CsWRKY7, homologous to AtWRKY7 and AtWRKY15, belongs to subgroup IId of WRKY family. AtWRKY7 transcription factor not only acted as a negative regulator in PAMP-mediated immune response but also participated in leaf senescence [34,35,36]. CsWRKY7 was abundant in old leaves and roots in tea plant, which was somewhat similar to the expression patterns of AtWRKY7 in Arabidopsis leaves, thus it could be speculated that CsWRKY7 might be involved in tea growth and development. Besides, CsWRKY7 gene expression was induced by various osmotic stresses and hormones exposure (Figure 3). Sequence analysis identified several potential stress-responsive elements in the promoter region including WBOXHVISO1, CCAATBOX1, GT1GMSCAM4, and MYB1AT and pollen-specific cis-regulatory elements (GTGANTG10), which participated in regulating the response to sugar, heat, NaCl, and drought stresses, respectively (Table 1). Some previous studies have reported that these cis-regulatory elements were stress-related. For example, MYB1AT existed in the promoter region of the Arabidopsis dehydration gene RD22, and GT1GMSCAM4 was present in the promoter region of the pathogen and salt-inducible gene SCaM-4, which consisted with the cis-regulatory elements in the promoter of CsWRKY7, suggesting that CsWRKY7 participated in various stress responses. (Figure 3) [37,38]. Though two pollen-specific cis-elements present in the promoter, the expression level of CsWRKY7 in flower was not significantly different from that in bud, which might be probably due to the complicated regulation mechanisms of gene expression. Besides, two hormone response elements—SA and auxin-response elements—are also found in this region. The hormone induction experiment showed that CsWRKY7 gene was responded to gibberellin and auxin treatment (NAA and 2,4-D), indicating that CsWRKY7 might also be involved in GA- and auxin- and abiotic stress-mediated signaling, but the corresponding mechanism remains be further explored.
Plant growth such as flowering, is a sophisticated regulated process that can be affected by diverse environmental stimuli. Previous research has reported that several WRKY members participate widely in plant growth and development. AtWRKY44 was reported to be involved in trichome and seed coat development in Arabidopsis [15]. AtWRKY4/-6/-7/-11/-57 were involved in leaf senescence [4]. WRKY transcription factors were involved in the regulation of plants flowering. For example, AtWRKY75 directly bound to the promoter region of FT gene, thereby positively regulating Arabidopsis flowering [27]. Both AtWRKY12 and AtWRKY13 transcription factors regulated Arabidopsis flowering time under short day [26]. Additionally, mango MlWRKY12 [24], soybean GsWRKY20 [23], and rice OsWRKY11 [25] also had a regulatory role in flowering. However, few studies of WRKY TFs in tea plant were reported, especially their functions related to plant development. In this study, its ORF was overexpressed in Arabidopsis to determine whether or not CsWRKY7 involved in plant growth. Transgenic analysis indicated that the overexpression of CsWRKY7 altered growth and flowering time of transgenic Arabidopsis (Figure 5 and Figure 6). Gene analysis showed that two meristem identity genes including AP1 and LFY were downregulated in transgenic Arabidopsis, compared with WT (Figure 6). Interestingly, previous studies have reported that there existed one or more W-boxes in the promoter region of AP1 and LFY [39]. As noted earlier, WRKY TFs could specifically bind to W-box [4,5,11,12,13]. Therefore, the reason why CsWRKY7 overexpressing lines delayed flowering may lie in that CsWRKY7 gene directly bound to the promoter regions of AP1 and LFY and inhibited their transcription levels.
However, FLC, a suppressor in flowering, was significantly downregulated in transgenic lines, while its homologous gene FLM was upregulated, indicating that FLM and FLC regulated flowering through different pathways. This finding was consistent with that of Katia (2003) [40]. CO gene encoding a B-box protein activated the transcription of FT. This study indicated that no difference in the expression level of CO was observed between transgenic lines and wild type, whereas the downstream gene FT was significantly inhibited, indicating that FT gene might be inhibited by other complexes such as PRC2, LHP1, SMZ, and TEM [41,42]. Hence, it could be speculated that CsWRKY7 gene may be involved in flowering regulation independent of the autonomous and vernalization pathway. Generally, these data support our hypothesis that CsWRKY7 delays flowering. The potential role of CsWRKY7 as a negative regulator in flowering sheds new light on the development of tea plants at transcription level, but its regulation mechanism should be further explored.
Although CsWRKY7 was induced by some abiotic stresses in C. sinensis, no significant difference in seed germination rate and seedling root growth was observed between CsWRKY7 overexpressing Arabidopsis lines and WT under abiotic stresses (salt, mannitol, PEG, and exogenous ABA) (Figure 4 and Figure 5), which might be possibly due to the lack of correlation between the levels of mRNA and protein encoded by CsWRKY7, or due to the effect of the inserted transgene on the phenotype. However, the function of CsWRKY7 gene in terms of osmotic stress response remains to be further characterized. The results of our study not only reveal an important role of CsWRKY7 in plant development, but also provide a foundation for breeding late-blooming tea plants.
To summarize, this study determined the response of CsWRKY7 to various abiotic stresses and hormones treatments. Our data revealed that CsWRKY7 delayed flowering and promoted root growth in Arabidopsis. Nevertheless, it is necessary to investigate further the pathways through which CsWRKY7 regulates both the development and stress response of tea plant.
4. Materials and Methods
4.1. Plant Materials, Growth Conditions, and Stress Treatments
Two-year-old tea seedlings (Camellia sinensis cv. ‘Longjing 43′) were grown in the greenhouse of Tea Research Institute of the Chinese Academy of Agricultural Sciences (TRICAAS).
The buds, tender stem, flowers, and roots, and leaves at different developmental stages were collected for tissue-specific analysis. The methods of abiotic stresses were essentially the same with those described in our previous research [43] and the materials were collected for further analysis. N. benthamiana was used for protein subcellular localization, and was grown in a climate chamber (24 ± 2 °C, 70% relative humidity, and 12 h/12 h light–dark photoperiod). A. thaliana ecotype, Columbia-0 (Col-0), was used as the background material and experiment control. The seeds of wild type and transgenic lines were surface sterilized with 75% ethanol and 0.01% (v/v) Tween-20 for 8–10 min, and then were washed by distilled water 3−4 times. The seeds were placed on 1/2 MS medium plate at 4 °C in darkness for 48 h, then grown in a climate incubator under a 16 h day/8 h night cycle, respectively at 22 °C/20 °C.
4.2. Cloning of CsWRKY7 Gene and Sequence Analysis
The expressed sequence tags (EST) were obtained from different transcriptome databases [44,45,46]. The full length of CsWRKY7 cDNA sequence was identified from different tissues of ‘Longjing 43′ by KOD DNA Polymerase (Toyobo, Tokyo, Japan) and RT-PCR. Gene-specific primers were as follows; 5′-ATGGCCGTCGAGCTCGTGAT-3′ (forward) and 5′-TCAAGAAGACTCTAAGATAAG-3′ (reverse). The purified RT-PCR products were inserted into pEASY-blunt simple cloning vector (TransGen Biotech, Beijing, China) and subsequently sequenced. The predicted molecular weight and theoretical isoelectric point were analyzed by ProtParam (http://web.expasy.org/protparam/, accessed on: 22 May 2017) [47]. The homology of CsWRKY7 protein with other species was analyzed by NCBI BLAST website. The amino acid sequences of WRKY II d subfamily members were analyzed by ClustalX 2.0 and DNAMAN 6.0 software. The MEGA 5.0 software was used to analyze their evolutionary relationships. CsWRKY7 genomic DNA (gDNA) sequence was searched in ‘Shuchazao’ tea plant genome database, and the promoter region was determined by aligning the open reading frames of the gDNA sequence and those of corresponding gene. The promoter region of CsWRKY7 (1680 bp upstream of start codon) was amplified from ‘Longjing 43′ gDNA by PCR using KOD DNA polymerase (Toyobo). The regulatory elements in promoter region were predicted by PlantCARE database (http://bioinformatics.psb.ugent.be/webtools/plantcare/html/, accessed on: 9 March 2019) [48].
4.3. Expression Patterns of CsWRKY7 in Tea Plant
Total RNA was extracted from the different tissues of ‘Longjing 43′ using QIAGEN RNeasy Mini Kit (Qiagen, Hilden, Germany). The reverse transcription reaction was carried out by FastKing gDNA Dispelling RT SuperMix RT Reagent Kit (TIANGEN, Beijing, China). Real-time PCR was performed on an optical 384-well plate with a LightCycler 480 machine (Roche, Sussex, UK). Each reaction contained 5 μL of SYBR Green I Master Mix (Roche Diagnostics), 1.0 μL cDNA samples, and 0.4 μM of each gene specific primer in a final volume of 10 μL. The glyceraldehyde-3-phosphate dehydrogenase (GAPDH) gene (accession no. FS952640) was used as an internal control. The expression levels were computed by the formula 2−ΔΔCt [49,50].
4.4. Subcellular Location Analysis
Using gateway cloning technology, CsWRKY7 full-length cDNA sequence without terminator codon was recombined into pH7FWG2 vector, containing the enhanced green fluorescent protein (eGFP) reporter gene, to generate 35s::CsWRKY7-eGFP fusion construct. Then, the recombinant plasmid (35s::CsWRKY7-eGFP) and the control (35s::GFP) were transformed into Agrobacterium tumefaciens EHA105 by freeze–thaw approach [51]. The confirmed bacteria were grown in yeast extract peptone (YEP) medium (pH = 7.4) at 28 °C until optical density at λ = 600 nm (OD600) to 1.0. This medium added with bacteria was centrifuged at 4000 rpm for 10 min. the sediment was resuspended with suspension buffer containing 10 mM MgCl2, 10 mM MES, and 100 μM acetosyringone (AS), with OD600 adjusted to 0.4. The suspension was infiltrated into well-developed N. benthamiana leaves. After infiltration, the tobacco plant was cultured in darkness for 48 h at 24 °C and then put in light for half an hour. The GFP signal was observed by a confocal microscopy. Additionally, cellular localization of the CsWRKY7-eGFP proteins in lateral roots of transgenic Arabidopsis plants was also observed by confocal microscopy.
4.5. Generation of CsWRKY7 Transgenic Plants
Gene-specific primers 5′-CACCATGGCGGTCGAGCTAG-3′ (Forward) and 5′-AGAAGACTCTAAAATGAGACCAGA-3′ (Reverse) were used to clone the open reading frame (ORF) of CsWRKY7. The cloned products were inserted into pENTR/D-TOPO vector (Invitrogen, Carlsbad, CA, USA) and sequenced, then the right directional sequence was inserted into pH7FWG2 vector with LR clonase II enzyme mix (Invitrogen) according to the manufacturer’s instructions. The binary vector was transferred into Agrobacterium tumefaciens strain GV3101 by freeze–thaw method [51], and then this strain was introduced into Arabidopsis by floral dip approach [52]. T4 homozygous seeds were used for the experiments.
4.6. Phenotypic Analysis of Transgenic Arabidopsis
For the germination assay, the seeds of WT and homozygous 35S::CsWRKY7 transgenic lines were germinated on 1/2 Murashige and Skoog (MS) medium containing different concentrations of NaCl (0, 100, 150, 200 mM), mannitol (0, 100, 200 mM), ABA (0, 0.3, 1, 10 μM), and PEG (0, 15%) solution. After 48-h vernalization, seedlings were placed vertically in climate incubator, and germination rate was counted on the fourth day. The germination was defined when the roots break the seed coat by 1 mm. Photographs of the plates with 150 mM NaCl, 200 mM mannitol, 0.3 μM ABA, and 15% PEG were taken on the 7th day. Each plate consisted of WT and three transgenic lines with 50 seeds per line in 9 cm diameter plate. In root length assay, the seeds of WT and homozygous 35S::CsWRKY7 transgenic lines were sown on 1/2 MS medium. After 48-h vernalization, the plates were placed vertically in climate incubator for 4 d. And then seedlings of similar size were transferred to different stress medium containing 150 mM NaCl, 200 mM Mannitol, 0.3 μM ABA, and 15% PEG, respectively. The root length was measured by ruler after 10-day growth. Arabidopsis seedlings were grown on 1/2 MS medium for 7–10 d, and then transplanted to sterilized soil in a growth chamber for the phenotype observation (16 h day/8 h night at 22/20 °C).
4.7. Quantitative Real-Time PCR Analysis in Transgenic Arabidopsis
To investigate the mechanism by which CsWRKY7 delayed flowering, the expression levels of flowering-related genes in transgenic Arabidopsis lines and wild type were calculated by the 2−ΔCt or 2−ΔΔCt with the expression level of Actin-2 gene (Gene Locus: At3g18780) as the reference control [49,50]. The primer sequence used for qRT-PCR are listed in Supplementary Table S1.
4.8. Statistical Analysis
All assays were performed with either three or more repetitive experiments. Student’s t-test was performed to determine the significant difference, and standard error were calculated using the Built-in Functions in Excel 2016. Student’s t-test, ‘*’, ‘**’, and ‘***’ indicate significant difference at p < 0.05, p < 0.01, and p < 0.001, respectively.
Supplementary Materials
Supplementary materials can be found at https://www.mdpi.com/1422-0067/20/11/2815/s1. Table S1 Primer sequences used for qRT-PCR.
Author Contributions
Data curation, M.-Z.Y. and L.C.; Formal analysis, D.-J.N. and L.C.; Investigation, Y.-X.X.; Methodology, W.C., W.-J.H., Y.-X.X., C.Z., and D.-J.N.; Project administration, L.C.; Resources, L.C.; Software, W.C., W.-J.H., and C.Z.; Supervision, M.-Z.Y. and L.C.; Validation, L.C.; Writing—original draft, W.C.; Writing—review and editing, M.-Z.Y. and L.C.
Funding
This work was supported by the Earmarked Fund for China Agriculture Research System (CARS-019) and the Chinese Academy of Agricultural Sciences through the Agricultural Science and Technology Innovation Program (CAAS-ASTIP-2017-TRICAAS) to Liang Chen.
Conflicts of Interest
The authors declare no conflicts of interest.
References
- Mitsuda, N.; Ohme-Takagi, M. Functional analysis of transcription factors in Arabidopsis. Plant Cell Physiol. 2009, 50, 1232–1248. [Google Scholar] [CrossRef] [PubMed]
- Chen, L.; Song, Y.; Li, S.; Zhang, L.; Zou, C.; Yu, D. The role of WRKY transcription factors in plant abiotic stresses. Biochim. Biophys. Acta 2012, 1819, 120–128. [Google Scholar] [CrossRef] [PubMed]
- Eulgem, T. Dissecting the WRKY web of plant defense regulators. PLoS Pathog. 2006, 2, e126. [Google Scholar] [CrossRef] [PubMed][Green Version]
- Eulgem, T.; Rushton, P.J.; Robatzek, S.; Somssich, I.E. The WRKY superfamily of plant transcription factors. Trends Plant Sci. 2000, 5, 199–206. [Google Scholar] [CrossRef]
- Rushton, P.J.; Macdonald, H.; Huttly, A.K.; Lazarus, C.M.; Hooley, R. Members of a new family of DNA-binding proteins bind to a conserved cis-element in the promoters of α-Amy2 genes. Plant Mol. Biol. 1995, 29, 691–702. [Google Scholar] [CrossRef] [PubMed]
- Rushton, P.J.; Torres, J.T.; Parniske, M.; Wernert, P.; Hahlbrock, K.; Somssich, I.E. Interaction of elicitor-induced DNA-binding proteins with elicitor response elements in the promoters of parsley PR1 genes. EMBO J. 1996, 15, 5690–5700. [Google Scholar] [CrossRef]
- Bakshi, M.; Oelmüller, R. WRKY transcription factors: Jack of many trades in plants. Plant Signal. Behav. 2014, 9, e27700. [Google Scholar] [CrossRef]
- Ishiguro, S.; Nakamura, K. Characterization of a cDNA encoding a novel DNA-binding protein, SPF1, that recognizes SP8 sequences in the 5′ upstream regions of genes coding for sporamin and β-amylase from sweet potato. Mol. Gen. Genet. 1994, 244, 563–571. [Google Scholar] [CrossRef]
- Miao, Y.; Smykowski, A.; Zentgraf, U. A novel upstream regulator of WRKY53 transcription during leaf senescence in Arabidopsis thaliana. Plant Biol. 2008, 10, 110–120. [Google Scholar] [CrossRef]
- Phukan, U.J.; Jeena, G.S.; Shukla, R.K. WRKY transcription factors: Molecular regulation and stress responses in plants. Front. Plant Sci. 2016, 7, 760. [Google Scholar] [CrossRef]
- Agarwal, P.; Reddy, M.P.; Chikara, J. WRKY: Its structure, evolutionary relationship, DNA-binding selectivity, role in stress tolerance and development of plants. Mol. Biol. Rep. 2011, 38, 3883–3896. [Google Scholar] [CrossRef] [PubMed]
- Ciolkowski, I.; Wanke, D.; Birkenbihl, R.P.; Somssich, I.E. Studies on DNA-binding selectivity of WRKY transcription factors lend structural clues into WRKY-domain function. Plant Mol. Biol. 2008, 68, 81–92. [Google Scholar] [CrossRef] [PubMed]
- Bao, W.; Wang, X.; Chen, M.; Chai, T.; Wang, H. A WRKY transcription factor, PcWRKY33, from Polygonum cuspidatum reduces salt tolerance in transgenic Arabidopsis thaliana. Plant Cell Rep. 2018, 37, 1033–1048. [Google Scholar] [CrossRef] [PubMed]
- Lagacé, M.; Matton, D.P. Characterization of a WRKY transcription factor expressed in late torpedo-stage embryos of Solanum chacoense. Planta 2004, 219, 185–189. [Google Scholar] [CrossRef] [PubMed]
- Ishida, T.; Hattori, S.; Sano, R.; Inoue, K.; Shirano, Y.; Hayashi, H.; Shibata, D.; Sato, S.; Kato, T.; Tabata, S.; et al. Arabidopsis TRANSPARENT TESTA GLABRA2 is directly regulated by R2R3 MYB transcription factors and is involved in regulation of GLABRA2 transcription in epidermal differentiation. Plant Cell 2007, 19, 2531–2543. [Google Scholar] [CrossRef] [PubMed]
- Luo, M.; Dennis, E.S.; Berger, F.; Peacock, W.J.; Chaudhury, A. MINISEED3 (MINI3), a WRKY family gene, and HAIKU2 (IKU2), a leucine-rich repeat (LRR) KINASE gene, are regulators of seed size in Arabidopsis. Proc. Natl. Acad. Sci. USA 2005, 102, 17531–17536. [Google Scholar] [CrossRef] [PubMed]
- Robatzek, S.; Somssich, I.E. A new member of the Arabidopsis WRKY transcription factor family, AtWRKY6, is associated with both senescence- and defence-related processes. Plant J. 2001, 28, 123–133. [Google Scholar] [CrossRef]
- Chen, L.; Xiang, S.; Chen, Y.; Li, D.; Yu, D. Arabidopsis WRKY45 interacts with the DELLA protein RGL1 to positively regulate age-triggered leaf senescence. Mol. Plant 2017, 10, 1174–1189. [Google Scholar] [CrossRef]
- Xie, Y.; Huhn, K.; Brandt, R.; Potschin, M.; Bieker, S.; Straub, D.; Doll, J.; Drechsler, T.; Zentgraf, U.; Wenkel, S. REVOLUTA and WRKY53 connect early and late leaf development in Arabidopsis. Development 2014, 141, 4772–4783. [Google Scholar] [CrossRef]
- Jiang, Y.; Liang, G.; Yang, S.; Yu, D. WRKY57 functions as a node of convergence for jasmonic acid- and auxin-mediated signaling in jasmonic acid–induced leaf senescence. Plant Cell 2014, 26, 230–245. [Google Scholar] [CrossRef]
- Besseau, S.; Li, J.; Palva, E.T. WRKY54 and WRKY70 co-operate as negative regulators of leaf senescence in Arabidopsis thaliana. J. Exp. Bot. 2012, 63, 2667–2679. [Google Scholar] [CrossRef] [PubMed]
- Jiang, W.; Yu, D.; Zou, C. Male gametophyte-specific WRKY34 transcription factor mediates cold sensitivity of mature pollen in Arabidopsis. J. Exp. Bot. 2010, 61, 3901–3914. [Google Scholar] [CrossRef]
- Zhu, D.; Cai, H.; Wu, J.; Cao, L.; Tang, L.; Hu, M.; Ji, W.; Bai, X.; Sun, X.; Liu, X.; et al. Expression of wild soybean WRKY20 in Arabidopsis enhances drought tolerance and regulates ABA signalling. J. Exp. Bot. 2013, 64, 2155–2169. [Google Scholar] [CrossRef]
- Yu, Y.; Hu, R.; Wang, H.; Cao, Y.; He, G.; Fu, C.; Zhou, G. MlWRKY12, a novel Miscanthus transcription factor, participates in pith secondary cell wall formation and promotes flowering. Plant Sci. 2013, 212, 1–9. [Google Scholar] [CrossRef] [PubMed]
- Cai, Y.; Chen, X.; Xie, K.; Xing, Q.; Wu, Y.; Li, J.; Du, C.; Sun, Z.; Guo, Z. Dlf1, a WRKY transcription factor, is involved in the control of flowering time and plant height in rice. PLoS ONE 2014, 9, e102529. [Google Scholar] [CrossRef] [PubMed]
- Li, W.; Wang, H.; Yu, D. Arabidopsis WRKY transcription factors WRKY12 and WRKY13 oppositely regulate flowering under short-day conditions. Mol. Plant 2016, 9, 1492–1503. [Google Scholar] [CrossRef] [PubMed]
- Zhang, L.; Chen, L.; Yu, D. Transcription factor WRKY75 interacts with DELLA proteins to affect flowering. Plant Physiol. 2018, 176, 790–803. [Google Scholar] [CrossRef]
- Luo, Y.; Yu, S.; Li, J.; Li, Q.; Wang, K.; Huang, J.; Liu, Z. Molecular characterization of WRKY transcription factors that act as negative regulators of O-Methylated catechin biosynthesis in tea plants (Camellia sinensis L.). J. Agric. Food Chem. 2018, 66, 11234–11243. [Google Scholar] [CrossRef]
- Wu, Z.-J.; Li, X.-H.; Liu, Z.-W.; Li, H.; Wang, Y.-X.; Zhuang, J. Transcriptome-wide identification of Camellia sinensis WRKY transcription factors in response to temperature stress. Mol. Genet. Genomics 2016, 291, 255–269. [Google Scholar] [CrossRef]
- Wang, Y.; Shu, Z.; Wang, W.; Jiang, X.; Li, D.; Pan, J.; Li, X. CsWRKY2, a novel WRKY gene from Camellia sinensis, is involved in cold and drought stress responses. Biol. Plant. 2016, 60, 443–451. [Google Scholar] [CrossRef]
- Wang, P.; Yue, C.; Chen, D.; Zheng, Y.; Zhang, Q.; Yang, J.; Ye, N. Genome-wide identification of WRKY family genes and their response to abiotic stresses in tea plant (Camellia sinensis). Genes Genomics 2019, 41, 17–33. [Google Scholar] [CrossRef] [PubMed]
- Kim, K.-C.; Fan, B.; Chen, Z. Pathogen-induced Arabidopsis WRKY7 is a transcriptional repressor and enhances plant susceptibility to Pseudomonas syringae. Plant Physiol. 2006, 142, 1180–1192. [Google Scholar] [CrossRef]
- Vanderauwera, S.; Vandenbroucke, K.; Inzé, A.; van de Cotte, B.; Mühlenbock, P.; De Rycke, R.; Naouar, N.; Van Gaever, T.; Van Montagu, M.C.E.; Van Breusegem, F. AtWRKY15 perturbation abolishes the mitochondrial stress response that steers osmotic stress tolerance in Arabidopsis. Proc. Natl. Acad. Sci. USA 2012, 109, 20113–20118. [Google Scholar] [CrossRef]
- Arraño-Salinas, P.; Domínguez-Figueroa, J.; Herrera-Vásquez, A.; Zavala, D.; Medina, J.; Vicente-Carbajosa, J.; Meneses, C.; Canessa, P.; Moreno, A.A.; Blanco-Herrera, F. WRKY7, -11 and -17 transcription factors are modulators of the bZIP28 branch of the unfolded protein response during PAMP-triggered immunity in Arabidopsis thaliana. Plant Sci. 2018, 27, 242–250. [Google Scholar] [CrossRef] [PubMed]
- Rogers, H.J.; Bate, N.; Combe, J.; Sullivan, J.; Sweetman, J.; Swan, C.; Lonsdale, D.M.; Twell, D. Functional analysis of cis-regulatory elements within the promoter of the tobacco late pollen gene g10. Plant Mol. Biol. 2001, 45, 577–585. [Google Scholar] [CrossRef]
- Ko, Y.J.; Lee, S.; Song, K.; Park, S.-Y.; Ahn, I.; Bae, S.-C.; Lee, Y.H.; Hwang, D.-J. Heterologous expression of the Brassica rapa transcription factor BrWRKY7 enhances resistance against bacterial soft rot caused by Pectobacterium carotovorum in Arabidopsis. Plant Biotechnol. Rep. 2015, 9, 179–186. [Google Scholar] [CrossRef]
- Abe, H.; Urao, T.; Ito, T.; Seki, M.; Shinozaki, K.; Yamaguchi-Shinozaki, K. Arabidopsis AtMYC2 (bHLH) and AtMYB2 (MYB) function as transcriptional activators in abscisic acid signaling. Plant Cell 2003, 15, 63–78. [Google Scholar] [CrossRef]
- Park, H.C.; Kim, M.L.; Kang, Y.H.; Jeon, J.M.; Yoo, J.H.; Kim, M.C.; Park, C.Y.; Jeong, J.C.; Moon, B.C.; Lee, J.H.; et al. Pathogen- and NaCl-induced expression of the SCaM-4 promoter is mediated in part by a GT-1 box that interacts with a GT-1-like transcription factor. Plant Physiol. 2004, 135, 2150–2161. [Google Scholar] [CrossRef]
- Hamès, C.; Ptchelkine, D.; Grimm, C.; Thevenon, E.; Moyroud, E.; Gérard, F.; Martiel, J.L.; Benlloch, R.; Parcy, F.; Müller, C.W. Structural basis for LEAFY floral switch function and similarity with helix-turn-helix proteins. EMBO J. 2008, 27, 2628–2637. [Google Scholar] [CrossRef]
- Scortecci, K.; Michaels, S.D.; Amasino, R.M. Genetic interactions between FLM and other flowering-time genes in Arabidopsis thaliana. Plant Mol. Biol. 2003, 52, 915–922. [Google Scholar] [CrossRef]
- Farrona, S.; Thorpe, F.L.; Engelhorn, J.; Adrian, J.; Dong, X.; Sarid-Krebs, L.; Goodrich, J.; Turck, F. Tissue-specific expression of FLOWERING LOCUS T in Arabidopsis is maintained independently of polycomb group protein repression. Plant Cell 2011, 23, 3204–3214. [Google Scholar] [CrossRef] [PubMed]
- Lee, J.; Lee, I. Regulation and function of SOC1, a flowering pathway integrator. J. Exp. Bot. 2010, 61, 2247–2254. [Google Scholar] [CrossRef] [PubMed]
- Chen, W.; Xu, Y.-X.; Mao, J.; Hao, W.-J.; Liu, Y.-F.; Ni, D.-J.; Chen, L. Cloning and expression patterns of VQ-motif-containing proteins under abiotic stress in tea plant. Plant Growth Regul. 2019, 87, 277–286. [Google Scholar] [CrossRef]
- Wang, D.; Li, C.-F.; Ma, C.-L.; Chen, L. Novel insights into the molecular mechanisms underlying the resistance of Camellia sinensis to ectropis oblique provided by strategic transcriptomic comparisons. Sci. Hortic. 2015, 192, 429–440. [Google Scholar] [CrossRef]
- Li, C.-F.; Zhu, Y.; Yu, Y.; Zhao, Q.-Y.; Wang, S.-J.; Wang, X.-C.; Yao, M.-Z.; Luo, D.; Li, X.; Chen, L.; et al. Global transcriptome and gene regulation network for secondary metabolite biosynthesis of tea plant (Camellia sinensis). BMC Genom. 2015, 16, 560. [Google Scholar] [CrossRef] [PubMed]
- Liu, S.-C.; Jin, J.-Q.; Ma, J.-Q.; Yao, M.-Z.; Ma, C.-L.; Li, C.-F.; Ding, Z.-T.; Chen, L. Transcriptomic analysis of tea plant responding to drought stress and recovery. PLoS ONE 2016, 11, e0147306. [Google Scholar] [CrossRef] [PubMed]
- Gasteiger, E.; Hoogland, C.; Gattiker, A.; Duvaud, S.E.; Wilkins, M.R.; Appel, R.D.; Bairoch, A. Protein identification and analysis tools in the ExPASy server. Methods Mol. Biol. 1999, 112, 531–552. [Google Scholar] [CrossRef]
- Lescot, M.; Déhais, P.; Thijs, G.; Marchal, K.; Moreau, Y.; Van de Peer, Y.; Rouzé, P.; Rombauts, S. PlantCARE, a database of plant cis-acting regulatory elements and a portal to tools for in silico analysis of promoter sequences. Nucleic Acids Res. 2002, 30, 325–327. [Google Scholar] [CrossRef]
- Livak, K.J.; Schmittgen, T.D. Analysis of relative gene expression data using real-time quantitative PCR and the 2−ΔΔCT method. Methods 2001, 25, 402–408. [Google Scholar] [CrossRef]
- Schmittgen, T.D.; Livak, K.J. Analyzing real-time PCR data by the comparative CT method. Nat. Protoc. 2008, 3, 1101. [Google Scholar] [CrossRef]
- Weigel, D.; Glazebrook, J. Transformation of Agrobacterium using the freeze-thaw method. CSH Protoc. 2006, 2006. [Google Scholar] [CrossRef] [PubMed]
- Clough, S.J.; Bent, A.F. Floral dip: A simplified method for Agrobacterium-mediated transformation of Arabidopsis thaliana. Plant J. 1998, 16, 735–743. [Google Scholar] [CrossRef] [PubMed]
© 2019 by the authors. Licensee MDPI, Basel, Switzerland. This article is an open access article distributed under the terms and conditions of the Creative Commons Attribution (CC BY) license (http://creativecommons.org/licenses/by/4.0/).